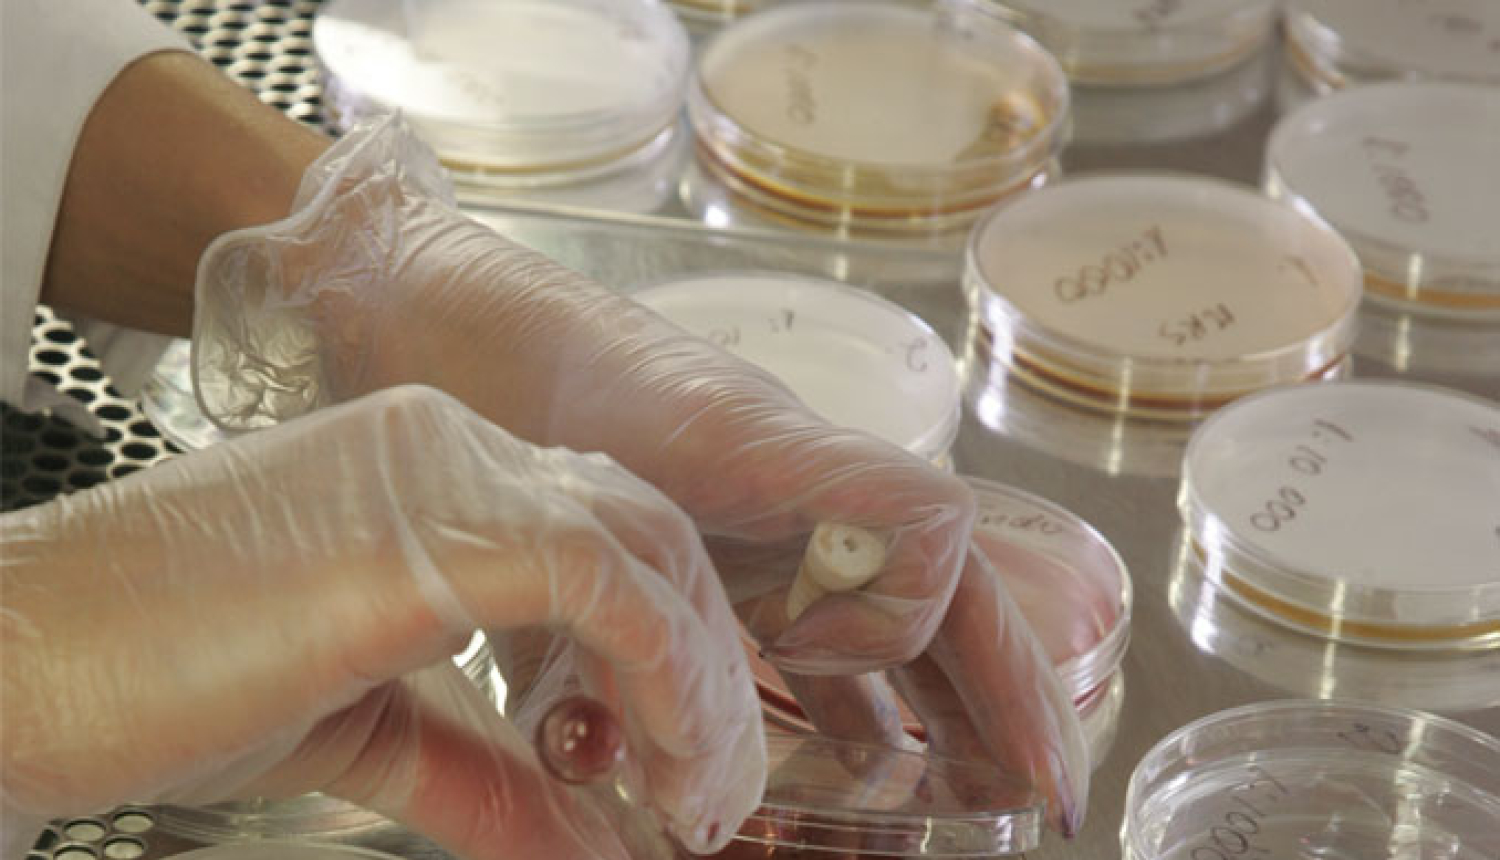
Stājušies spēkā Ministru kabineta noteikumi par starptautiskās sadarbības projektu pētniecībā un inovācijās finansēšanas nosacījumiem

Latvijas ekonomikas izaugsmei valdība turpmākajos sešos gados investēs 32,55 milj. eiro zinātnes un pētniecības starptautisko sadarbības tīklu paplašināšanas pasākumos, veicinot Latvijas zinātnieku iesaisti Eiropas pētniecības norisēs un Latvijas zinātnes integrāciju pasaules zinātnes telpā. No kopējām šim mērķim plānotajām investīcijām Eiropas Reģionālās attīstības fonda finansējums ir 27, 67 milj. eiro apmērā, bet valsts budžeta līdzfinansējums – 4, 88 milj. eiro.
Latvijas zinātnieku dalību starptautiskos pētniecības, tīklošanās un sadraudzības pasākumos, valdība 2017.gada 6.jūnijā pieņēma Izglītības un zinātnes ministrijas izstrādātos Ministru kabineta noteikumus nr. 315, kas nosaka kārtību, kādā īsteno pasākuma „Atbalsts starptautiskās sadarbības projektiem pētniecībā un inovācijās”. Pasākumu īstenošanā tiks iesaistītas zinātniskās institūcijas, zinātniskais personāls, Latvijas Republikas Uzņēmumu reģistrā reģistrētie komersanti, valsts iestādes un programmas “Apvārsnis 2020” Nacionālais kontaktpunkts. Investīcijas starptautisko pētniecības projektu īstenošanai tiks veiktas trijās projektu atlases kārtās. Katrai projektu atlasei ir izvirzīti atšķirīgi uzdevumi un plānotie rezultāti, līdz ar to arī paredzēta atšķirīga zinātnieku un komersantu iesaiste projektos un projektu atlases veids.
Pirmajai projektu atlases kārtai ir paredzēti 16, 6 miljoni eiro, un tā tiks organizēta ierobežotas projektu iesniegumu atlases veidā. Kā projektu iesniedzējus valdības apstiprinātie noteikumi nosaka Izglītības un zinātnes ministriju (turpmāk – ministrija) un Valsts izglītības attīstības aģentūru (turpmāk – aģentūra).
Ministrija projekta ietvaros īstenos pasākumus starptautiskās sadarbības tīklu paplašināšanai, tai skaitā nodrošinās Latvijas dalību starptautiskās pētniecības un attīstības sadarbības iniciatīvās, kā arī Latvijas zinātnes interešu pārstāvniecības stiprināšanu programmas “Apvārsnis 2020” programmkomitejās. Tāpat tiks uzsākta sadarbība ar diasporu ārvalstīs un Latvijas un ārvalstu ekonomiskajām un diplomātiskajām pārstāvniecībām kopīgu pētniecības un inovāciju projektu īstenošanai un sadarbības iespēju paplašināšanai. Projekta ietvaros tiks organizēts arī Pasaules Latviešu zinātnieku kongress.
Savukārt Aģentūra projektā plāno īstenot programmas “Apvārsnis 2020” Nacionālā kontaktpunkta darbības paplašināšanas un efektivitātes uzlabošanas pasākumus, t.sk. konsultācijas, mācību pasākumus, klientu datu bāzes izveidi, EURAXESS portāla nacionālās sadaļas pilnvērtīgas darbības nodrošināšanu. Tāpat projekta ietvaros tiks nodrošināta Latvijas dalība ERA-NET COFUND projektu konsorcijos - to ietvaros atvērtajos projektu konkursos iesniegto un atbalstīto pētniecības projektu Latvijas partneru projektu daļu finansēšana un uzraudzība. Aģentūras īstenotā projekta ietvaros tiks veikts arī Latvijas dalības izvērtējums programmā “Apvārsnis 2020”, kā arī programmas “Apvārsnis 2020” apakšprogrammu konkursos iesniegto un virs kvalitātes sliekšņa novērtēto projektu sagatavošanas finansēšana.
Pirmās kārtas projektus plānots īstenot līdz 2023. gada 30. novembrim.
Arī pasākuma otro kārtu ar 6,6 miljonu eiro finansējumu ir plānots īstenot ierobežotas projektu iesniegumu atlases veidā. Noteikumi paredz, ka projektu iesniedzēji būs 18 Latvijas spēcīgākās zinātniskās institūcijas.
Zinātniskās institūcijas savu projektu ietvaros varēs veikt institucionāla līmeņa pasākumus, kas ietver tīklošanās, mācību un mobilitātes pasākumus, lai iesaistītos starptautiskos konsorcijos un programmās. Projektu finansējumu varēs izmantot arī programmas “Apvārsnis 2020” un ES 9. Ietvara programmas projektu iesniegumu sagatavošanai, starptautisku zinātnisko konferenču organizēšanu Latvijā, Eiropas Kodolpētījumu organizācijas (CERN) Nacionālā kontaktpunkta rīcības plāna īstenošanai un sadarbības pasākumu īstenošanu kvantu skaitļošanas jomā (Latvijas Universitātes, Kvantu programmatūras pētniecības centra (Nīderlande) un Parīzes Kvantu skaitļošanas centra (Francija) sadarbība).
Otrās kārtas projektus plānots īstenot ne ilgāk kā līdz 2022. gada 31. decembrim.
Savukārt trešo atlases kārtu apstiprinātie noteikumi paredz īstenot atklātas projektu iesniegumu atlases veidā, projekta iesniedzējs ir zinātniskā institūcija. Šīs atlases kārtas kopējas finansējums ir 9, 6 miljoni eiro.
Trešās kārtas ietvaros atbalsts paredzēts programmas “Apvārsnis 2020” virs kvalitātes sliekšņa novērtētu, bet finansējumu nesaņēmušu projektu vai to daļu finansēšanai, kas, sākot ar 2015. gada 1. janvāri, ir iesniegti šādās programmas “Apvārsnis 2020” apakšprogrammās:
a) Izcilības izplatīšana un dalības paplašināšana (Spreading Excellence and Widening Participation) apakšprogramma ERA Chairs;
b) Marijas Sklodovskas – Kirī apakšprogrammas International Fellowships (IF) stipendijas;
c) Eiropas Zinātnes padomes (European Research Council) “Frontier Research” granti;
d) kopuzņēmuma ECSEL ietvaros apstiprināta projekta no ES struktūrfondiem finansējamas darba paketes atbalsts.
Trešās kārtas projektus varēs īstenot līdz 2023. gada 30. novembrim.